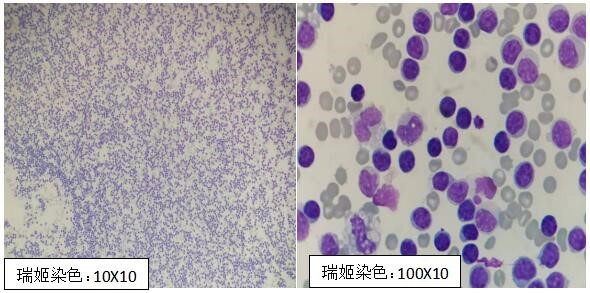

贵医大三附院开展了新项目——细胞形态学检查(新型的体液细胞形态学检查),是黔南州首家开展该项目的医院,也是省内少数几家开展该项目的医院之一。
这个项目到底有什么作用?用一句话形容,那就是“表面风平浪静,实则镜下险象重生”。看似普通疾病,通过该检查查出端倪,精准助力临床诊断,帮助患者及早接受治疗。下面一起来看几个案例。
案例一
患者,女,50岁,因身体不适入院检查,影像学发现有大量腹水。腹水细胞形态学检测发现异常细胞,通过病理检查,最终诊断为肿瘤。

案例二
患者,男性,因社区获得性肺炎反复治疗无效入院,影像学检查发现有胸水。胸水细胞学检测发现异常细胞,通过病理检查结果,最终诊断为肿瘤。

案例三
患者,男,20岁,因反复感冒、咳嗽入院,影像学检查发现有胸水,胸水检查未检出异常细胞及结核杆菌。胸水细胞学检测发现成熟淋巴细胞,结合胸水生化、影像检查,最终诊断为结核性胸水。
案例四
患者,男,30岁,因运动损伤踝关节入院,影像学检查发现有关节腔积液,尿酸检测值在正常范围。关节腔积液细胞学检测发现尿酸盐结晶。结合临床症状,最终诊断为痛风。

我院检验科积极开展新技术新项目,为临床诊治提供有力支持,更好地服务患者。